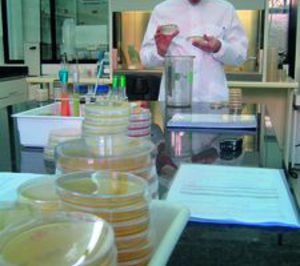
Laboratorio Oliver Rodés amplía instalaciones

Ampliará su oferta de servicios, destinados, entre otros, al sector de aguas envasadas y la industria alimentaria. El laboratorio de análisis de aguas ...

Adquiere una nave y alcanza los 2.200 m2
Ampliará su oferta de servicios, destinados, entre otros, al sector de aguas envasadas y la industria alimentaria. El laboratorio de análisis de aguas ...
¿Ya estás registrado? Gestionar sin cuenta Alimarket
Marca los sectores que te interesan y recibirás una newsletter diaria con los titulares de las principales noticias